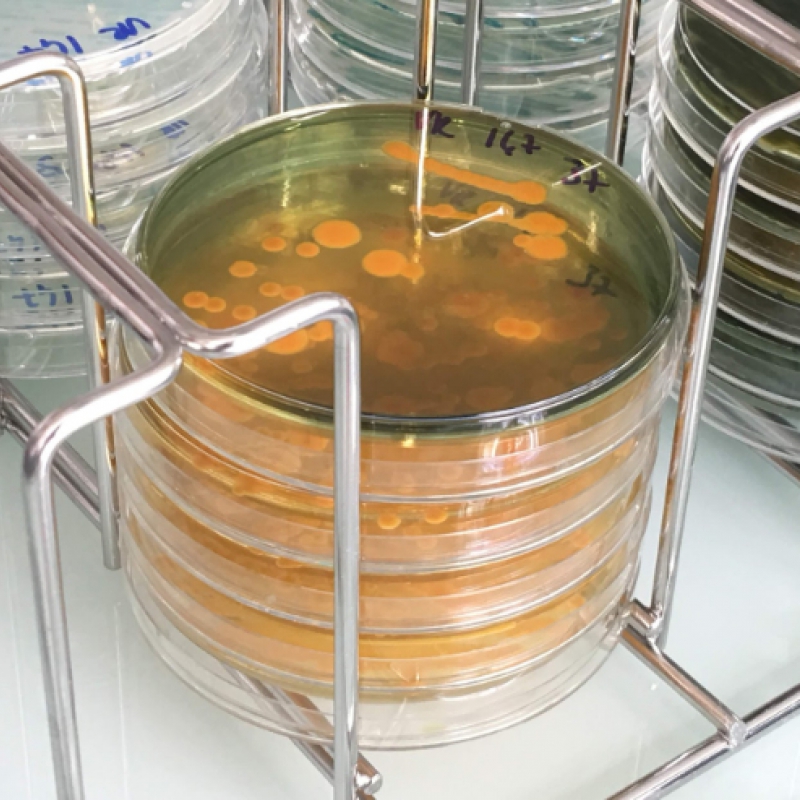

40 chercheurs sont installés à l’ANSES de Boulogne sur mer !

Le bâtiment de l’ANSES, Agence nationale de sécurité sanitaire s’est agrandit au port de Boulogne sur mer. Les laboratoires abritent une quarantaine de chercheurs. Leurs missions : détecter les parasites et les micro-plastiques dans les produits de la mer !
Anne Brisabois est directrice du site boulonnais de l’ANSES. Elle coordonne aussi les recherches avec les étudiants de l’ULCO :
Depuis 5 ans, la recherche étudie l’impact du plastique dans les mers et océans. On sait depuis que le plastique est ingéré par le poisson puis par l’homme. Reste à déterminer les effets secondaires…
Guillaume Duflos, directeur adjoint de l’ANSES à Boulogne sur mer :
L’extension de l’ANSES a été financée par la Région 575 000 euros, l’anses 492 000 euros et l’agglomération boulonnaise pour 90 000 euros.